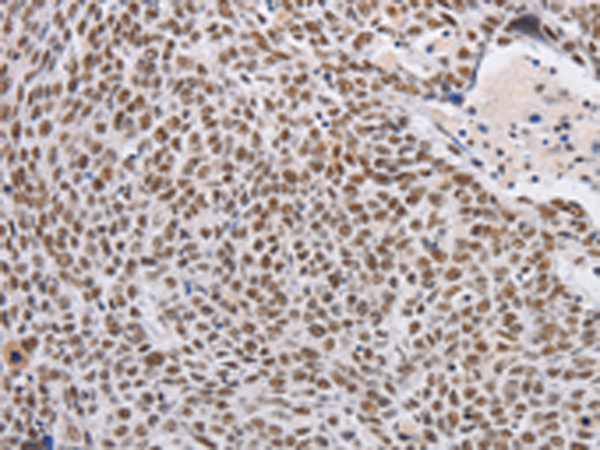

|
Background: |
Required for efficient export of polyadenylated RNA. Acts as component of the THO subcomplex of the TREX complex which is thought to couple mRNA transcription, processing and nuclear export, and which specifically associates with spliced mRNA and not with unspliced pre-mRNA. TREX is recruited to spliced mRNAs by a transcription-independent mechanism, binds to mRNA upstream of the exon-junction complex (EJC) and is recruited in a splicing- and cap-dependent manner to a region near the 5' end of the mRNA where it functions in mRNA export to the cytoplasm via the TAP/NFX1 pathway. The TREX complex is essential for the export of Kaposi's sarcoma-associated herpesvirus (KSHV) intronless mRNAs and infectious virus production. |
|
Applications: |
ELISA, WB, IHC |
|
Name of antibody: |
THOC7 |
|
Immunogen: |
Fusion protein of human THOC7 |
|
Full name: |
THO complex 7 |
|
Synonyms: |
fSAP24; hTREX30; NIF3L1BP1 |
|
SwissProt: |
Q6I9Y2 |
|
ELISA Recommended dilution: |
2000-5000 |
|
IHC positive control: |
Human lung cancer |
|
IHC Recommend dilution: |
25-100 |
|
WB Predicted band size: |
24 kDa |
|
WB Positive control: |
Mouse spleen and human fetal liver tissue, hela cells and mouse testis tissue, A431 cells |
|
WB Recommended dilution: |
500-2000 |

購物車
購物車 幫助
幫助
 021-54845833/15800441009
021-54845833/15800441009
